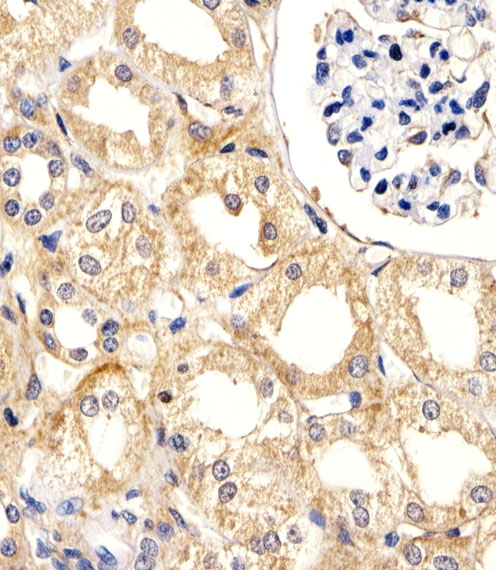

别名:Ubiquitin-conjugating enzyme E2 L3, L-UBC, UbcH7, Ubiquitin carrier protein L3, Ubiquitin-conjugating enzyme E2-F1, Ubiquitin-protein ligase L3, UBE2L3, UBCE7, UBCH7应用:WB,IHC
反应种属:Human, Mouse, Rat
规格:50μl/100μl
| Description |
|---|
| The modification of proteins with ubiquitin is an important cellular mechanism for targeting abnormal or short-lived proteins for degradation. Ubiquitination involves at least three classes of enzymes: ubiquitin-activating enzymes (E1s), ubiquitin-conjugating enzymes (E2s) and ubiquitin-protein ligases (E3s). This gene encodes a member of the E2 ubiquitin-conjugating enzyme family. This enzyme is demonstrated to participate in the ubiquitination of p53, c-Fos, and the NF-kB precursor p105 in vitro. Several alternatively spliced transcript variants have been found for this gene. |
| Specification | |
|---|---|
| Aliases | Ubiquitin-conjugating enzyme E2 L3, L-UBC, UbcH7, Ubiquitin carrier protein L3, Ubiquitin-conjugating enzyme E2-F1, Ubiquitin-protein ligase L3, UBE2L3, UBCE7, UBCH7 |
| Entrez GeneID | 7332 |
| Swissprot | P68036 |
| WB Predicted band size | 17.9kDa |
| Host/Isotype | Rabbit IgG |
| Storage | Store at 4°C short term. Aliquot and store at -20°C long term. Avoid freeze/thaw cycles. |
| Species Reactivity | Human, Mouse, Rat |
| Immunogen | This UBE2L3 antibody is generated from rabbits immunized with a KLH conjugated synthetic peptide between 106-135 amino acids from the C-terminal region of human UBE2L3. |
| Formulation | Purified polyclonal antibody supplied in PBS with 0.05% sodium azide. This antibody is purified through a protein A column, followed by peptide affinity purification. |
| Application | |
|---|---|
| WB | 1/1000 |
| IHC | 1/100-1/500 |
![]() |
UBE2L3 Antibody (C-term) (Cat. #P32316) western blot analysis in K562,U87-MG,mouse NIH/3T3,rat PC-12 cell line and mouse testis,rat testis tissue lysates (35ug/lane).This demonstrates the UBE2L3 antibody detected the UBE2L3 protein (arrow). |
![]() |
Immunohistochemical analysis of paraffin-embedded H.kidney section using UBE2L3 Antibody (C-term)(Cat#P32316). P32316 was diluted at 1:25 dilution. A peroxidase-conjugated goat anti-rabbit IgG at 1:400 dilution was used as the secondary antibody, followed by DAB staining. |
本公司的所有产品仅用于科学研究或者工业应用等非医疗目的,不可用于人类或动物的临床诊断或治疗,非药用,非食用。
暂无评论
本公司的所有产品仅用于科学研究或者工业应用等非医疗目的,不可用于人类或动物的临床诊断或治疗,非药用,非食用。
中文

发表回复